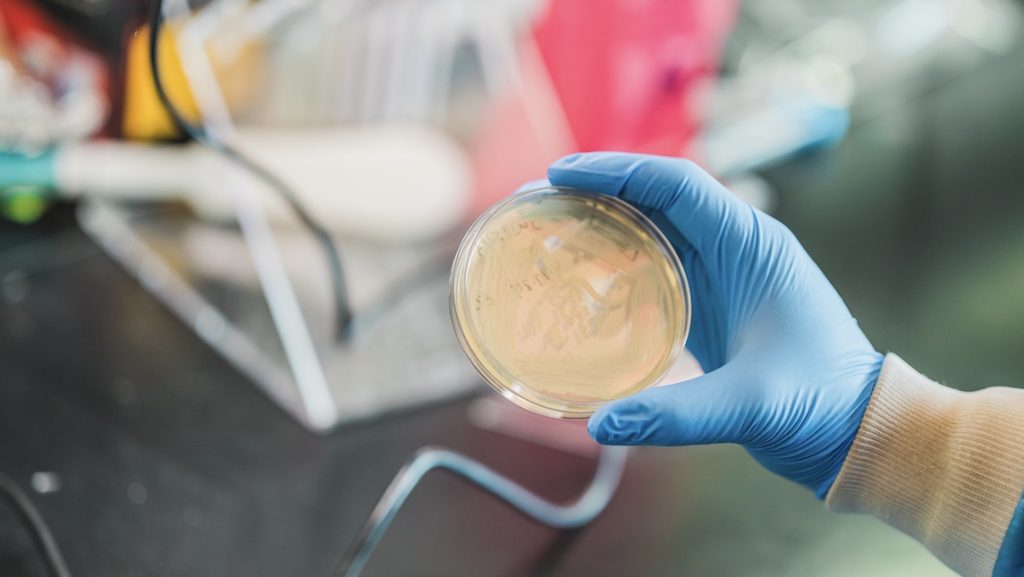
Hand wearing a blue latex glove holding a petri dish in a laboratory setting.

Joy, enthusiasm, energy — this is what emanates from even a brief interaction with Dennis LaJeunesse, longtime nanoscience professor at UNC Greensboro’s Joint School of Nanoscience and Nanoengineering (JSNN).
As he concludes a 26-year career at the University, he seems thrilled to mentor JSNN graduate students, support innovative research, and collaborate with colleagues as if it were his first year of teaching.
“The past year has been so exciting,” he says. “There have been so many papers published, so many graduations, and so many students defending. I want to get students excited about their achievements.”
LaJeunesse identifies graduate school as the “most favorite time in my life,” and he has gone to great lengths throughout his career to ensure JSNN students experience the same.
Pathway to Nanoscience
Talking to LaJeunesse quickly reveals he is a man of many passions.
His undergraduate experience included majors in both classics and biology, with the hopes of being an archaeologist, as well as wrestling and fencing.
Following graduation, odd jobs — like being a fencing coach, an asbestos abatement technician, and a waiter — kept him busy, but he could not ignore his curiosity about science, so he applied for graduate school at Johns Hopkins University.
“Being in graduate school was freeing, so full of possibility and potential,” says LaJeunesse. “I had the opportunity to glean information from many different sources, allowing me to better understand what was happening in the world around me.”
After completing his doctoral degree in biology, LaJeunesse came to North Carolina to work at Duke University as a postdoctoral research fellow for almost five years before landing a professorship in Greensboro.

JSNN Professor Dennis LaJeunesse has influenced the academic, professional, and personal lives of many JSNN students. Read their stories!
The Joy of Graduate School
While in graduate school, LaJeunesse felt grounded by the scientific process, knowing other scientists had achieved hard things before him. He believed he could do the same if he were patient, broke problems into bite-sized pieces, and worked within a community.
At JSNN, he’s strived to instill the same sentiment in his mentorship of students.
“JSNN allows me to work with students from all over the world and in different disciplines, like physics, computer science, and engineering,” LaJeunesse says. “I see my role as getting these students prepped for their next steps.”
Students need to realize there is humility involved in being a scientist and conducting research, he explains, but with patience and dedication, they can and will move forward.
“That’s why I encourage students to include all their research in their dissertations — even the processes that did not work — because something was still learned,” LaJeunesse says.
His students have heard this message loud and clear.
Recent graduate Patience Kwara ’25 worked with LaJeunesse on an applied research project producing probiotic gummies.
“Although we did not achieve the desired results, the learning process was fun,” she says. “Dr. LaJeunesse encouraged us to keep working and not give up despite our setbacks.”
Current JSNN student Quadejia Crockett calls LaJeunesse a “life-changing mentor.”
“He did not just teach me the material,” she says. “He also taught me to ask better questions and to believe in my abilities.”
Innovation in the Lab and the Classroom
With 13 publications in 2025 and three more coming in 2026, LaJeunesse’s research with students overflows with activity.
He currently has several students working with bacteria-produced nanocellulose. When derived from paper or wood, the nanocellulose is contaminated, but when produced from bacteria, it is crystalline, or very pure, and can functionalize materials that could potentially support advanced wound healing.
Other research includes looking at nanomaterial interactions with bacteria and yeast, in which model systems, like Escherichia coli, or baker’s yeast, and Candida albicans, a fungus that helps balance yeast levels in the body, are used to see how nanomaterials interact with them — how they change or how they grow.
This research is to better understand how cells respond to subtle changes in the physical environment, which could possibly improve the effectiveness of antifungal drugs.
JSNN PhD candidate Maurelio Cabo Jr. appreciates LaJeunesse’s support in research pursuits.
“He is open to discussing ideas and shaping research directions together, which has helped us publish five first-author papers from my research topics and also made my experience rewarding,” says Cabo.
Beyond research, LaJeunesse developed a communications course to teach students how to effectively write a proposal, how to design a National Institutes of Health study section, and how to provide feedback on research writing.


Mentorship Beyond the Lab
While LaJeunesse is a favored mentor within the lab, his ability to bring students together outside of the lab is just as vital to their growth.
“It’s important to find ways to build community amongst your students,” he says. “You want to create a really tight group of scientists.”
And he actively has created these spaces for JSNN students to bond, whether it is leading a yoga class, renting a gazebo at Lake Jeanette in Greensboro, or hosting a lab meeting at Jake’s Billiards.
Ensuring students share experiences outside of the lab guarantees they will cooperate and collaborate well within the lab, thinks LaJeunesse.
Leadership and Legacy at JSNN
LaJeunesse has served as JSNN’s director of graduate studies, a position in which he helped organize both the department and the curriculum to make it most beneficial for fellow faculty as well as students.
By optimizing courses and curriculum, he added more stability to the department.
“If the system is built correctly, it should perpetuate with success no matter who is in charge,” he says.
He applauds his fellow faculty, calling them an “eclectic group of scientists.” Due to the multiple fields being under the JSNN umbrella, he sees so much potential for growth, particularly with young new faculty members.
As he wraps up his time on campus, he hopes he’s offered his students what he experienced in graduate school.
“These students have done a great job for me,” he says. “I hope I paid it back by maximizing their learning, enhancing their joy, and celebrating their accomplishments.”
Written by Amy Burtch, AMBCopy
Photos by Sean Norona, University Communications, and provided by JSNN